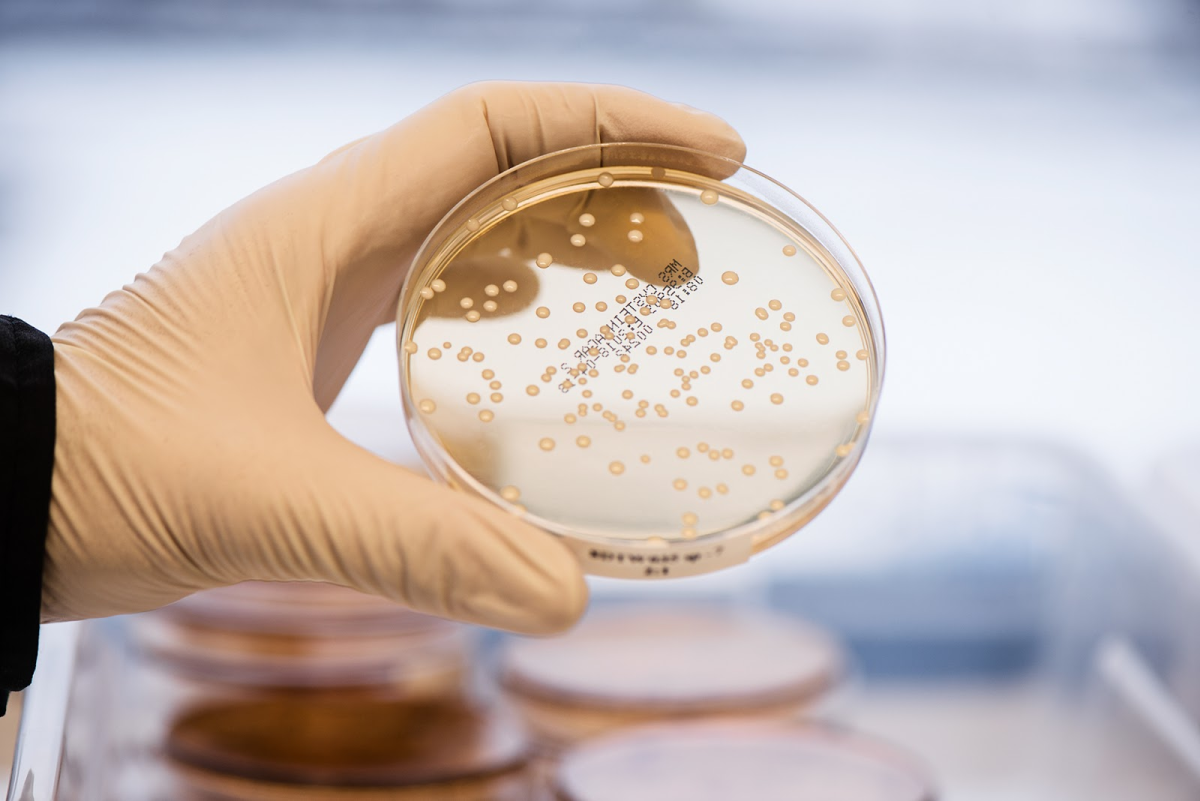

BioGaia Protectis probiotics originate from Sweden, a country renowned for its stringent healthcare standards. Each BioGaia product is the result of decades of research and a rigorous manufacturing process, meticulously controlled from research to distribution.
 |
Scientists at work in BioGaia's research laboratory in Eslov, Sweden. Photo: Biogaiagroup |
Scientists at work in BioGaia's research laboratory in Eslov, Sweden. Photo: Biogaiagroup
Over 35 years, collaborating with a network of over 50 research institutes globally, BioGaia has successfully developed numerous probiotic products. Notably, the BioGaia Protectis Baby Drops product line represents over 200,000 hours of research by BioGaia experts. This extensive research ensures product safety, making them suitable for sensitive individuals, including newborns and premature infants.
The proprietary probiotic strain, Lactobacillus reuteri Protectis, is the key differentiator and driver of BioGaia products' effectiveness. According to the US National Center for Biotechnology Information, this isn't just an ordinary probiotic strain; it's one of the most thoroughly researched probiotics worldwide.
L. reuteri Protectis offers multifaceted action, providing comprehensive digestive support. It cultivates an ideal gut environment by producing natural antibacterial substances like reuterin, lactic acid, and acetic acid. These substances eliminate and inhibit harmful bacteria, fostering the growth of beneficial bacteria and establishing a balanced, healthy microbiome.
|
A petri dish containing cultured bacterial colonies. Photo: Biogaiagroup |
A petri dish containing cultured bacterial colonies. Photo: Biogaiagroup
By positively influencing intestinal motility and blocking the TRPV-1 pain receptor through neurotransmitter release, this probiotic strain alleviates digestive discomfort.
L. reuteri Protectis also strengthens the epithelial barrier, enhancing intestinal lining integrity.
The quality and efficacy of L. reuteri Protectis are not only substantiated by over 180 clinical studies but also recognized and recommended by leading medical organizations such as the World Gastroenterology Organisation (WGO) and the European Society for Paediatric Gastroenterology, Hepatology and Nutrition (Espghan).
 |
A scientist uses a pipette to add solution to a petri dish in the laboratory. Photo: Biogaiagroup |
A scientist uses a pipette to add solution to a petri dish in the laboratory. Photo: Biogaiagroup
Significantly, L. reuteri Protectis has twice received the US Food and Drug Administration's (FDA) highest safety rating - GRAS (Generally Recognized As Safe), certifications number 254 and 410, affirming its safety for long-term use across all ages.
"This clinical data validates the product's effectiveness and is key to BioGaia earning the trust and loyalty of numerous experts and consumers," a brand representative stated.
BioGaia's 10-year journey in the Vietnamese market extends beyond providing quality products. It's a pioneering effort in educating the market about the importance of probiotics and overall digestive health.
 |
The Asia-Pacific Probiotics Scientific Conference organized by BioGaia in Da Nang. Photo: BioVagen |
The Asia-Pacific Probiotics Scientific Conference organized by BioGaia in Da Nang. Photo: BioVagen
As Vietnam progresses, BioGaia pledges continued investment in research, development, and innovation to maintain the highest product quality. They aim to provide science-backed healthcare solutions, contributing to the healthy development of future generations.
The Dan












